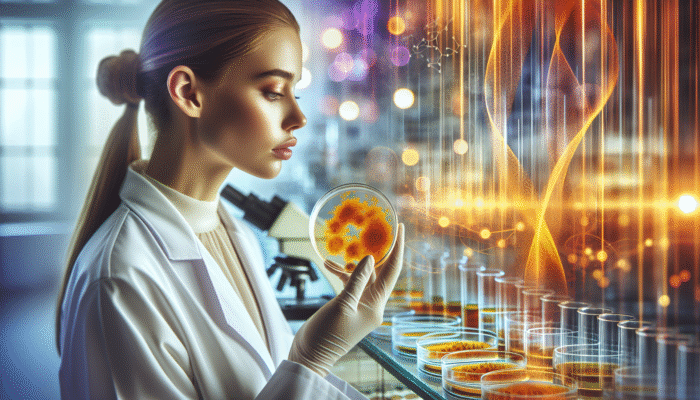

Unlocking the Health Advantages of Turmeric and Its Impact on Inflammation Reduction
Diving Deeper into Turmeric: A Remarkable Spice with Healing Qualities

Turmeric is a strikingly vibrant yellow spice derived from the root of the plant Curcuma longa, renowned for its vivid color and a plethora of health advantages. This extraordinary spice serves not only as a culinary enhancer but also boasts a long-standing history of medicinal use that spans thousands of years. The primary active component in turmeric, known as curcumin, has garnered significant attention in turmeric inflammation research for its potential health-promoting properties. Curcumin is recognized for its powerful anti-inflammatory and antioxidant capabilities, prompting extensive investigations into its role as a therapeutic agent for a wide array of health conditions marked by inflammation.
The global intrigue surrounding turmeric extends far beyond its culinary uses. As a fundamental element in traditional medicine systems like Ayurveda and Traditional Chinese Medicine, turmeric has been utilized to address a multitude of health concerns, ranging from digestive issues to chronic inflammatory diseases. Its adaptability allows for numerous consumption methods, including powders, capsules, and teas, making it accessible to a wide audience eager to reap its health-enhancing benefits. As its presence expands within modern health and wellness discourses, turmeric is increasingly valued as more than merely a spice; it embodies holistic health practices that are embraced by diverse cultures worldwide.
Inflammation: A Key Player in Health and Disease
Inflammation represents a complex biological response that acts as a vital mechanism within the body’s defense system. When the body faces injury or infection, the immune system triggers an inflammatory response aimed at promoting healing and protection. Acute inflammation serves a critical role in combating pathogens and initiating repair processes. Conversely, chronic inflammation can have deleterious health consequences, contributing to a multitude of diseases, including heart disease, diabetes, and various autoimmune disorders.
Chronic inflammation is often labeled a “silent killer” due to its ability to progress without overt symptoms, ultimately leading to a gradual decline in overall health. Factors like environmental influences, lifestyle choices, and pre-existing health conditions can exacerbate this issue, making it essential for individuals to understand the root causes of inflammation. The convergence of modern science and traditional wisdom emphasizes the significance of dietary and lifestyle modifications, including the incorporation of turmeric inflammation research, as effective strategies for successfully combating chronic inflammation.
Exploring the Fascinating Link Between Turmeric and Inflammation
Research has identified a significant correlation between turmeric's active compound, curcumin, and its remarkable anti-inflammatory properties, making it a centerpiece in turmeric inflammation research. Numerous studies illustrate that curcumin can impact various inflammatory pathways, effectively lowering markers of inflammation throughout the body. This compelling association has fueled a growing interest in turmeric as a natural alternative to conventional anti-inflammatory medications, which frequently pose the risk of adverse side effects.
The therapeutic potential of curcumin arises from its ability to target crucial molecular pathways involved in the inflammatory process, such as nuclear factor kappa B (NF-kB) and cyclooxygenase-2 (COX-2). By inhibiting these pathways, curcumin reduces the production of pro-inflammatory cytokines, resulting in decreased inflammation. Additionally, the rising trend toward natural remedies has prompted extensive research into turmeric's efficacy across diverse populations, underscoring its importance in the fight against chronic inflammatory diseases.
Delving into Scientific Investigations of Turmeric and Inflammation
A Thorough Review of Clinical Trials Investigating Turmeric
A plethora of clinical trials has emerged, scrutinizing the effects of turmeric and curcumin on inflammation and associated health conditions. These studies span multiple continents, reflecting the widespread interest in turmeric's potential therapeutic benefits. In recent years, clinical trials have focused on its efficacy in managing conditions such as arthritis, inflammatory bowel disease, and even cardiovascular diseases.
Results from these trials indicate that curcumin supplementation can lead to significant decreases in inflammatory markers, including C-reactive protein (CRP) and interleukin-6 (IL-6), across varied populations. For example, a meta-analysis examining several clinical studies revealed that curcumin supplementation resulted in a noticeable reduction in joint pain and swelling among individuals diagnosed with osteoarthritis, a condition frequently characterized by chronic inflammation. Such findings have prompted further investigations into the optimal dosage, formulation, and long-term effects of turmeric, contributing valuable insights to the ever-expanding field of turmeric inflammation research.
The international breadth of these trials is impressive; researchers from Asia to North America have played pivotal roles in this body of work, reinforcing the spice's significance across diverse cultures. Furthermore, as the evidence base continues to grow, it underscores the necessity for collaboration between traditional knowledge and contemporary scientific methods to optimize the health benefits of turmeric on a global scale.
Key Discoveries from Turmeric Research
Numerous studies have highlighted turmeric's impressive capacity to alleviate inflammation-related diseases. Research indicates that curcumin not only reduces inflammatory markers but also lessens symptoms associated with chronic inflammatory conditions. For instance, a randomized controlled trial conducted in Europe demonstrated that curcumin supplementation significantly improved symptoms of rheumatoid arthritis, showcasing its potential as a complementary therapy for managing such debilitating conditions.
Additionally, research encompassing diverse demographics—from athletes seeking recovery to older populations grappling with inflammatory diseases—indicates that curcumin can enhance overall well-being. A systematic review that includes trials from Asia and North America revealed that curcumin supplementation improved inflammatory markers in participants with metabolic syndrome, suggesting its utility in preventing chronic diseases linked to inflammation.
These findings carry profound implications, highlighting not only turmeric's anti-inflammatory properties but also its potential role in preventive health care. By advocating for further exploration into curcumin's therapeutic applications, researchers are paving the way for innovative treatments that could offer relief from chronic inflammation on a global scale.
Recognizing Challenges and Future Research Directions

Despite the encouraging outcomes from turmeric inflammation research, several limitations must be acknowledged when interpreting current study findings. One primary concern is the bioavailability of curcumin, which is notoriously low. Many clinical trials utilize high doses of curcumin in isolated forms, raising questions about how these results translate into everyday dietary practices. Research aimed at enhancing curcumin's bioavailability is crucial for addressing this challenge, with studies investigating the use of piperine, an alkaloid found in black pepper, showing promise in this area.
Future research should also concentrate on the long-term effects and optimal dosages of turmeric supplementation across diverse populations. Variations in individual responses to curcumin suggest that personalized approaches to dosing may be essential to maximize its anti-inflammatory benefits. Additionally, studies examining turmeric's effects alongside other dietary interventions could enhance its efficacy through synergistic effects.
As an increasing number of individuals globally pursue natural alternatives to pharmaceutical medications, ongoing research into turmeric's effects on inflammation will likely play a crucial role in shaping public health policies and dietary recommendations. With the integration of traditional knowledge and modern science, the future of turmeric as a therapeutic agent appears bright.
Investigating Mechanisms of Action in Inflammation
The mechanisms by which curcumin exerts its anti-inflammatory effects are intricate and multifaceted. Research indicates that curcumin influences several key pathways involved in the inflammatory response. A significant aspect of its action is its ability to inhibit the production of pro-inflammatory mediators while simultaneously enhancing the body’s natural anti-inflammatory responses.
Studies demonstrate that curcumin interacts directly with various molecular targets, including cytokines, growth factors, and enzymes regulating the inflammatory process. For instance, curcumin has been shown to inhibit tumor necrosis factor-alpha (TNF-α), a critical pro-inflammatory cytokine involved in systemic inflammation. By lowering TNF-α levels, curcumin can alleviate symptoms associated with chronic inflammatory conditions, solidifying its role as a central focus in turmeric inflammation research.
In addition to its direct anti-inflammatory effects, curcumin also possesses antioxidant properties that play a crucial role in reducing oxidative stress. Oxidative stress is a significant factor in the development and progression of inflammation-related diseases. By neutralizing free radicals, curcumin helps protect cells from oxidative damage, further enhancing its anti-inflammatory effects.
Understanding the Anti-Inflammatory Pathways Activated by Curcumin
Curcumin's ability to activate specific anti-inflammatory pathways underscores its role as a natural agent against inflammation. One primary pathway influenced by curcumin is the nuclear factor (erythroid-derived 2)-like 2 (Nrf2) pathway, which is vital in regulating the body's antioxidant defense mechanisms. By activating Nrf2, curcumin boosts the expression of antioxidant enzymes and promotes cellular protection against inflammation.
Moreover, curcumin modulates other signaling pathways associated with inflammation, such as mitogen-activated protein kinases (MAPKs). These pathways are integral to the regulation of pro-inflammatory cytokines and chemokines. By inhibiting MAPK activation, curcumin effectively reduces the production of these inflammatory mediators, further contributing to its anti-inflammatory effects.
Additionally, curcumin's impact on the phosphoinositide 3-kinase (PI3K) and Akt pathways highlights its multifaceted approach to managing inflammation. By influencing these pathways, curcumin can promote cell survival and anti-inflammatory responses, enhancing its therapeutic potential in preventing and treating chronic inflammatory diseases. The exploration of these pathways provides invaluable insights into the mechanisms underpinning curcumin's effects, reinforcing the significance of ongoing turmeric inflammation research.
Synergistic Effects of Curcumin with Other Bioactive Compounds
Combining curcumin with other bioactive compounds can amplify its anti-inflammatory effects, providing a holistic approach to managing inflammation. Studies have demonstrated that co-administering curcumin with piperine enhances its bioavailability, allowing for more efficient absorption and a greater overall impact on inflammation. This synergy not only improves curcumin's efficacy but also emphasizes the significance of combining natural ingredients to optimize health outcomes.
Moreover, curcumin can work harmoniously with other anti-inflammatory compounds found in foods, such as gingerol in ginger and quercetin in onions and apples. The interplay between these compounds can lead to enhanced therapeutic benefits, as they collectively target various pathways involved in inflammation. Research exploring these combinations is still in its infancy, yet preliminary findings suggest that such multi-ingredient approaches could revolutionize how we address inflammatory diseases.
The growing global interest in natural remedies underscores the potential for developing synergistic formulations that harness the power of multiple compounds. By focusing on the interactions between curcumin and other bioactive substances, researchers can pave the way for innovative treatments that cater to the diverse needs of populations worldwide, solidifying turmeric's position in the realm of turmeric inflammation research.
The Role of Curcumin in Reducing Oxidative Stress
Curcumin's potent antioxidant properties significantly contribute to its ability to combat oxidative stress, which is a crucial factor in chronic inflammation. Oxidative stress occurs when there is an imbalance between free radicals and antioxidants in the body, leading to cellular damage and inflammation. By neutralizing free radicals, curcumin helps restore cellular balance and mitigate the inflammatory response.
Research shows that curcumin enhances the activity of various antioxidant enzymes, such as superoxide dismutase (SOD) and glutathione peroxidase. By promoting the expression of these enzymes, curcumin fortifies the body's natural defense mechanisms against oxidative stress. This interplay between curcumin's antioxidant and anti-inflammatory effects emphasizes its dual role in supporting overall health.
Furthermore, the impact of curcumin on oxidative stress has been extensively examined across diverse populations. For example, research indicates that curcumin supplementation can improve oxidative stress markers in individuals with metabolic syndrome, showcasing its potential to alleviate inflammation-related conditions. As our comprehension of curcumin's antioxidant properties expands, its implications for global health become increasingly significant, reinforcing the necessity for further turmeric inflammation research.
Modulating Gene Expression Through Curcumin
Curcumin's ability to modulate gene expression is a pivotal aspect of its anti-inflammatory effects. By influencing the transcription of specific genes, curcumin promotes the expression of anti-inflammatory proteins while suppressing pro-inflammatory ones. This regulation of gene expression occurs through various signaling pathways, including NF-kB and Nrf2, which are crucial in the inflammatory response.
Research indicates that curcumin can downregulate the expression of genes associated with inflammation, such as those encoding cytokines and enzymes that play a role in the inflammatory process. By inhibiting these genes, curcumin effectively reduces the inflammatory response, contributing to its therapeutic potential in managing chronic inflammatory diseases.
Additionally, curcumin's effects on transcription factors further underscore its role in modulating inflammation. By interacting with these critical proteins, curcumin can influence the overall inflammatory landscape within the body, promoting a shift toward a more balanced immune response. The exploration of curcumin's effects on gene expression provides valuable insights into its mechanisms of action, reinforcing the importance of ongoing turmeric inflammation research in developing effective therapeutic applications.
Turmeric's Legacy in Traditional Healing Practices
Tracing the Historical Significance of Turmeric
Turmeric carries a rich history within traditional medicine systems, particularly in Ayurveda, where it has been revered for centuries as a potent remedy for inflammation and a multitude of ailments. Its historical uses span over 4,000 years, with documentation highlighting its application in treating digestive issues, skin conditions, and joint pain. The integration of turmeric into cultural practices emphasizes its significance as a holistic healing agent, embraced by countless communities around the globe.
As a cornerstone of Ayurvedic medicine, turmeric's anti-inflammatory properties have established it as a staple in traditional remedies. The ancient practice of utilizing turmeric paste for topical applications to soothe skin irritations and wounds exemplifies its versatility. Furthermore, turmeric is often consumed in various forms, such as golden milk—a cherished beverage made from milk, turmeric, and spices—highlighting its role in daily health rituals.
The enduring popularity of turmeric in traditional medicine attests to its effectiveness and cultural significance. As modern scientific research increasingly substantiates the therapeutic benefits of turmeric, the fusion of traditional knowledge with contemporary inquiry presents an exciting opportunity for the global community to harness its potential in managing inflammation-related health issues.
Traditional Remedies Incorporating Turmeric
A variety of traditional remedies and preparations featuring turmeric exemplify its anti-inflammatory properties and cultural significance. Golden milk, a warm beverage crafted with turmeric, milk (or plant-based alternatives), and spices such as cinnamon and ginger, is widely enjoyed across South Asia. This nourishing drink serves not only as a culinary delight but also as a popular home remedy for reducing inflammation and promoting overall wellness.
In addition to golden milk, traditional Ayurvedic practices often incorporate turmeric into various formulations, such as pastes and powders for topical application. These preparations are utilized to alleviate skin conditions, bruises, and joint pain, showcasing turmeric's versatility as a healing agent. Furthermore, turmeric is also integrated into food as a spice, offering both flavor and health benefits.
The wisdom surrounding these traditional remedies continues to be passed down through generations, emphasizing the importance of cultural heritage in health practices. As awareness of turmeric's benefits expands globally, there exists an opportunity to integrate these traditional preparations into modern health and wellness strategies, enriching the global understanding of turmeric's potential in managing inflammation.
Modern Applications of Traditional Wisdom in Turmeric Usage
The synthesis of traditional knowledge with modern research presents exciting possibilities for optimizing turmeric's application in addressing inflammation. As the global community increasingly recognizes the value of herbal remedies, there is a renewed interest in exploring how traditional practices can inform contemporary health approaches.
Collaborative efforts between researchers and traditional healers can lead to innovative formulations that combine turmeric with other beneficial herbs and spices, enhancing its efficacy in managing inflammation. For instance, the synergy between turmeric and ginger in both traditional and modern contexts has garnered attention in turmeric inflammation research, presenting a compelling avenue for further exploration.
Moreover, public health initiatives aimed at promoting the use of turmeric in daily diets can empower individuals to take charge of their health. Educational programs that underscore the historical significance and contemporary applications of turmeric can foster a deeper understanding of its potential in disease prevention and management. As the world continues to embrace holistic health practices, the marriage of traditional wisdom with modern scientific inquiry will undoubtedly shape the future of turmeric's applications in combating inflammation.
Incorporating Turmeric into Your Diet and Supplements
Effective Ways to Add Turmeric to Your Daily Meals
Incorporating turmeric into your daily diet is an excellent way to harness its extraordinary anti-inflammatory properties. This versatile spice can be seamlessly added to a variety of dishes, from hearty curries and stir-fries to nutritious smoothies and soups. Its vibrant color and distinct flavor not only elevate culinary experiences but also contribute to overall health and well-being.
One popular method to consume turmeric is by preparing turmeric lattes or golden milk, where the spice is blended with milk (or plant-based alternatives) along with other spices like cinnamon and ginger. This comforting beverage offers not only a delicious treat but also a potent dose of curcumin, enhancing anti-inflammatory benefits.
Another innovative way to incorporate turmeric is by adding turmeric powder to smoothies or protein shakes. This enhances the flavor while boosting the nutritional content. As more individuals worldwide strive to improve their health through dietary choices, the inclusion of turmeric offers a simple yet effective solution to combat inflammation and promote overall wellness.
Understanding Turmeric Supplements and Ideal Dosage
Turmeric supplements have gained popularity as a concentrated source of curcumin, providing individuals with a convenient option to experience its health benefits. However, understanding optimal dosages and formulations is critical for maximizing the therapeutic potential of turmeric. Most studies investigating curcumin's effects have utilized dosages ranging from 500 mg to 2,000 mg daily, often divided into multiple doses throughout the day.
While supplements can offer significant advantages, it is essential to consult healthcare professionals before initiating any new regimen, particularly for individuals with underlying health conditions or those taking medications. Personalized recommendations can assist in determining the appropriate dosage and formulation to achieve the desired anti-inflammatory effects.
Importantly, individuals should also be aware of the differences in bioavailability among various turmeric supplements. Some formulations incorporate enhancers like piperine, which can significantly increase curcumin absorption, making it a more effective option for those seeking to combat inflammation. As global interest in turmeric continues to grow, understanding the nuances of turmeric supplementation will empower individuals to make informed choices for their health.
Improving Bioavailability and Absorption of Curcumin
Enhancing the bioavailability of turmeric is a crucial consideration in optimizing its anti-inflammatory effects. Curcumin is notorious for its low bioavailability, meaning that only a small percentage is absorbed into the bloodstream upon consumption. This limitation has prompted extensive research into strategies for increasing curcumin absorption, ensuring that individuals can effectively benefit from its therapeutic properties.
One promising method for improving curcumin's bioavailability involves the addition of piperine, an alkaloid found in black pepper. Studies indicate that piperine can increase curcumin absorption by up to 2000%, making it a valuable addition to turmeric supplements and culinary preparations. This synergistic relationship enhances the overall efficacy of curcumin, amplifying its potential to reduce inflammation.
Furthermore, integrating turmeric into meals that contain healthy fats can also aid in absorption. Curcumin is fat-soluble, which means it is more effectively absorbed in the presence of dietary fats. By pairing turmeric with healthy fats found in foods such as avocado or coconut oil, individuals can optimize their intake of curcumin while enjoying flavorful dishes.
As our understanding of turmeric's bioavailability continues to evolve, individuals can leverage these insights to enhance the anti-inflammatory benefits of this remarkable spice. With a global community increasingly focused on health optimization, the ongoing exploration of turmeric's absorption will play a crucial role in shaping dietary practices and wellness strategies.
Evaluating Safety and Possible Side Effects of Turmeric
Understanding the General Safety Profile of Turmeric
Turmeric is generally regarded as safe when consumed in culinary amounts, making it a widely embraced spice across various cultures. Its historical use in traditional medicine systems, combined with numerous scientific studies, supports its safety profile for most individuals. However, while turmeric can offer remarkable health benefits, it is essential to be aware of potential side effects, particularly when taken in high doses or concentrated forms.
Research suggests that moderate consumption of turmeric in food poses minimal health risks. Nonetheless, high doses may lead to gastrointestinal discomfort, such as nausea or diarrhea. Additionally, individuals with specific health conditions, such as gallbladder disease or those taking blood-thinning medications, should exercise caution and consult healthcare providers before using turmeric supplements or high doses of curcumin.
Navigating the balance between therapeutic benefits and safety is crucial for maximizing the health advantages of turmeric. By understanding the spice's safety profile, individuals can confidently incorporate turmeric into their diets while reaping its anti-inflammatory rewards.
Identifying Potential Interactions and Contraindications
While turmeric is generally safe, it may interact with certain medications and medical conditions, necessitating caution for some individuals. For instance, turmeric can enhance the effects of anticoagulants, increasing the risk of bleeding. Those taking medications such as warfarin or aspirin should consult healthcare professionals prior to incorporating turmeric supplements into their regimen.
Moreover, individuals with gallstones or bile duct obstructions should approach turmeric cautiously, as high doses may exacerbate symptoms. Pregnant or breastfeeding women are also advised to consult healthcare providers before significantly increasing turmeric intake, as research on its effects during pregnancy remains limited.
Recognizing these potential interactions is vital for individuals seeking to incorporate turmeric into their health routines. Open communication with healthcare professionals can help identify potential contraindications, ensuring that individuals can enjoy the benefits of turmeric safely.
Monitoring Adverse Effects and Reporting Concerns
Monitoring for any adverse effects associated with turmeric is essential for contributing to ongoing research and safety assessments. Although adverse reactions are rare for most individuals consuming turmeric in culinary amounts, those who experience discomfort or unusual symptoms when using turmeric supplements should document their experiences.
Healthcare providers can play a pivotal role in reporting any adverse effects, facilitating a better understanding of turmeric's safety profile across diverse populations. The ongoing collection and analysis of data will inform future research efforts, ultimately enhancing our knowledge of turmeric's impact on health and safety.
By cultivating a culture of reporting and monitoring, individuals can contribute valuable insights to the growing body of turmeric inflammation research, ensuring that the spice continues to be recognized for its potential benefits while minimizing associated risks.
Guidelines for Recommended Dosage and Administration
Adhering to recommended dosages of turmeric and curcumin is crucial for minimizing risks and maximizing benefits. While the optimal dosage can vary depending on individual health needs and conditions, a general guideline suggests a range between 500 mg to 2,000 mg of curcumin daily. This dosage is typically divided into multiple doses throughout the day to enhance absorption and effectiveness.
Choosing the right form of turmeric is also important. Turmeric powder can be easily incorporated into meals, while capsules or supplements may provide a concentrated source of curcumin for those seeking specific health outcomes. Consulting healthcare professionals can assist individuals in tailoring their turmeric regimen to suit their unique health goals and conditions.
As the global community continues to embrace turmeric for its anti-inflammatory properties, understanding recommended dosages and administration methods will empower individuals to make informed choices that enhance their well-being.
Turmeric's Influence on Chronic Inflammatory Diseases
Examining Turmeric's Benefits for Chronic Health Conditions
The impact of turmeric on chronic inflammatory diseases is a focal point of contemporary research, with numerous studies highlighting its potential benefits across various conditions. For individuals suffering from inflammatory bowel diseases, such as Crohn's disease and ulcerative colitis, curcumin has emerged as a promising adjunct therapy. Research indicates that curcumin can help reduce disease activity, alleviate symptoms, and improve the quality of life for individuals grappling with these challenging conditions.
Similarly, in the realm of autoimmune disorders such as rheumatoid arthritis and lupus, curcumin's anti-inflammatory properties have shown promise in providing relief from debilitating symptoms. Clinical trials have demonstrated that curcumin supplementation can lead to significant reductions in pain, swelling, and overall disease activity in patients with rheumatoid arthritis, reinforcing its potential as a natural alternative to traditional anti-inflammatory medications.
Furthermore, growing evidence suggests that curcumin may play a role in managing chronic conditions associated with metabolic syndrome, including obesity, diabetes, and cardiovascular disease. Studies indicate that curcumin can help improve insulin sensitivity, reduce fat accumulation, and lower cholesterol levels, all of which are crucial factors in preventing the progression of these chronic diseases.
As research continues to uncover the intricate relationships between turmeric and chronic inflammatory diseases, the potential for curcumin to serve as a complementary therapy is becoming increasingly evident. By addressing the underlying causes of inflammation and promoting overall health, turmeric holds promise as a powerful ally in the fight against chronic diseases.
Utilizing Turmeric for Preventive Health Strategies
Turmeric's role in preventive health is gaining recognition as individuals seek proactive approaches to maintaining well-being. The anti-inflammatory properties of curcumin position it as a valuable tool in preventing the onset of chronic diseases linked to inflammation. By incorporating turmeric into daily diets, individuals can harness its health benefits and promote a balanced immune response.
Research suggests that a diet rich in anti-inflammatory foods, including turmeric, may lower the risk of developing chronic diseases such as heart disease, diabetes, and certain cancers. By integrating turmeric into meals, individuals can enhance their overall nutritional intake and support their body's natural defenses against inflammation.
Moreover, public health initiatives promoting the consumption of turmeric as part of a balanced diet can empower individuals to take control of their health. Educational programs highlighting the benefits of turmeric in preventive health can inspire communities to adopt healthier eating habits, ultimately leading to improved health outcomes on a global scale.
As our understanding of turmeric's role in preventive health expands, the potential for curcumin to serve as a cornerstone in dietary recommendations becomes increasingly salient. By fostering awareness and accessibility, individuals can embrace turmeric as a natural ally in their pursuit of long-term health and well-being, reinforcing its significance in the landscape of turmeric inflammation research.
Future Research Directions and Opportunities for Turmeric
The future of turmeric and its applications in managing inflammation presents numerous research opportunities that warrant exploration. Ongoing studies focused on understanding the optimal dosages, formulations, and synergistic effects of curcumin with other bioactive compounds can help refine its therapeutic potential. Additionally, exploring the impact of turmeric on diverse populations will enrich our understanding of its effectiveness across various cultural contexts.
Future research should also target the limitations surrounding curcumin's bioavailability, as enhancing absorption will be critical in maximizing its anti-inflammatory benefits. Innovative delivery systems and formulations that improve curcumin bioavailability could pave the way for its widespread use in clinical settings.
Moreover, the integration of traditional knowledge with modern scientific approaches presents exciting possibilities for turmeric's applications in public health. Collaborations between researchers, healthcare professionals, and traditional healers can lead to the development of holistic health strategies that harness the power of turmeric while respecting cultural practices.
As turmeric inflammation research continues to evolve, it offers a multitude of avenues for exploration that can inform future health recommendations and therapeutic interventions. The journey of turmeric as a global health ally is just beginning, and the possibilities for its use in combating chronic inflammation are boundless.
Reflecting on the Health Advantages of Turmeric
Turmeric stands as a testament to the synergy between tradition and modern science, embodying the potential to contribute significantly to health and well-being. Its rich history and evolving understanding of its anti-inflammatory properties position turmeric as an invaluable ally in combating chronic inflammation and related diseases. As more individuals globally seek natural alternatives to conventional treatments, the ongoing exploration of turmeric's benefits will undoubtedly shape future health paradigms.
By embracing turmeric as a dietary staple and a holistic healing agent, individuals can empower themselves to take charge of their health. With insights gained from turmeric inflammation research, the world is poised to unlock the full potential of this ancient spice, paving the way for a healthier future.
Common Inquiries Regarding Turmeric and Inflammation
What is turmeric and how does it assist with inflammation?
Turmeric is a spice derived from the root of Curcuma longa, recognized for its active compound curcumin, which possesses potent anti-inflammatory properties that aid in reducing inflammation-related symptoms and fostering overall health.
What are the health benefits associated with turmeric?
Turmeric provides a range of health benefits, including anti-inflammatory effects, antioxidant properties, support for joint health, improved digestion, and potential protection against chronic diseases such as heart disease and diabetes.
How can I include turmeric in my diet?
Turmeric can be easily incorporated into your diet by adding it to soups, curries, smoothies, and teas. Golden milk, a popular beverage made with turmeric, is also a delightful way to enjoy its advantages.
Are turmeric supplements effective?
Yes, turmeric supplements can be effective in providing concentrated doses of curcumin. However, it is important to consult a healthcare provider for suitable dosages and formulations tailored to individual health needs.
What side effects are associated with turmeric?
Turmeric is generally safe when consumed in culinary amounts; however, high doses may result in gastrointestinal discomfort. Individuals with specific health conditions or those on certain medications should consult healthcare providers before using turmeric supplements.
How does curcumin impact the body at a molecular level?
Curcumin interacts with key molecular targets in the body, modulating inflammatory pathways, inhibiting pro-inflammatory cytokines, and activating antioxidant defenses, ultimately leading to reduced inflammation.
Can turmeric be used in conjunction with conventional medications?
Turmeric may interact with certain medications, especially blood thinners. It is crucial to consult a healthcare professional before combining turmeric with other treatments to avoid potential complications.
What is the recommended dosage of turmeric for managing inflammation?
The recommended dosage of turmeric typically ranges from 500 mg to 2,000 mg of curcumin daily, depending on individual health needs and conditions. Consultation with a healthcare provider is advisable for personalized recommendations.
What role does turmeric play in traditional healing practices?
Turmeric has a long-standing history in traditional medicine systems, such as Ayurveda, where it has been utilized for its anti-inflammatory properties to treat various ailments, highlighting its cultural significance and therapeutic potential.
What future research opportunities are available for turmeric and inflammation?
Future research opportunities include exploring optimal dosages, enhancing curcumin's bioavailability, examining synergistic effects with other compounds, and integrating traditional knowledge with modern scientific approaches to optimize turmeric's health benefits.
Connect with us on Facebook!
The Article Turmeric Inflammation Research: A Comprehensive Guide appeared first on https://athleticsupplement.com





Comments are closed